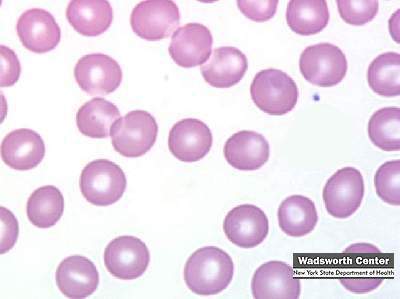
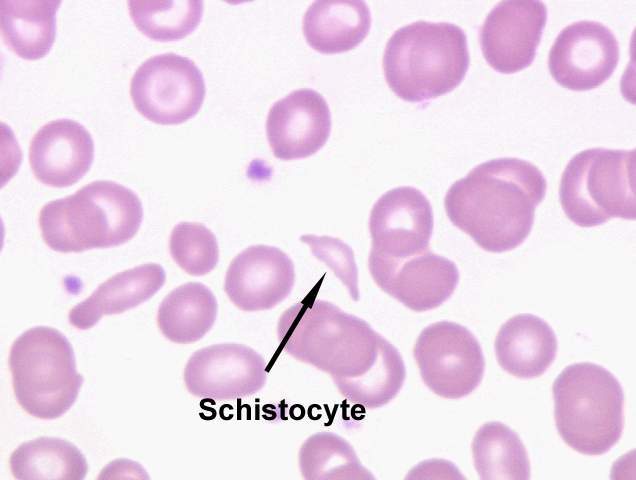

Erythrocyte, or “red blood cell” (RBC). Despite the common term, this is not a cell at all, although it’s derived from true cells. The RBC is the mature stage of development of a cell line in which the nucleus (present in earlier forms) has been lost.
erithrocytes (red) with platelets (purple)
Platelets are little bitty things, only 2 to 4 microns in diameter (about half the size of an RBC), and round to oval in shape. They have a central zone that is slightly basophilic, and a pale, homogeneous periphery. Look for them in the spaces between erythrocytes. The image above shows platelets in a smear: they appear as small fragments with a blue cast to them. They’re much smaller than the erythrocytes: maybe 1-3 microns. The scanning electron micrograph at the right is of a group of platelets which have begun to initiate a clot. The stringy material covering them is fibrin, the matured, insoluble fibrillar component of blood.

segmented neutrophil
Neutrophils are the most common form of leukocyte in primates, dogs, cats, and horses. They have other names, frequently encountered in clinical literature: “polys” or “PMNs” are most common, both abbreviations for “polymorphonuclear leukocyte.” These cells can be identified on a smear by their size (about 9 to 12 microns diameter) and their characteristically segmented or lobulated nucleus. The nucleus in its mature form may have 3 to 5 lobes, connected together with fine threads of nuclear material. The granules in the cytoplasm are usually lightly stained, and may appear to be pink to purple. This variability of staining has resulted in the name “heterophil” being applied to these cells.
Neutrophil
The one in the smear shown here is from a monkey. Specifically, a female monkey. The extensive lobulation of the nucleus has produced a drumstick shape lobe, a “Barr Body” (named for Murray L. Barr, 1908-1995, a Canadian anatomist) which represents the extra X chromosome in females.

Eosinophils are much less common than neutrophils. They’re the same size or even slightly larger (10 to 14 microns) and their cytoplasmic granules are strongly eosinophilic, staining a bright orange-pink color. Typically the nucleus is bi-lobed, not multi-lobed as in the neutrophils. There’s some species variation in eosinophils. The granules are exceptionally large in horses (slide 1006) and it would be worth your while to compare the “typical” eosinophils from dogs and cats with those of the horse. Their function isn’t completely understood, but it’s known that eosinophils are involved in allergic responses.
Like the granules of neutrophils, the eosinophil’s granules contain lytic enzymes, but they’re much larger than those of neutrophils, and they stain pinkish red in Wright’s smears. The staining reaction is the most characteristic means of identifying these cells.
Another useful clue is the nuclear morphology. Eosinophils never show the extensive nuclear lobulation typical of the neutrophil, but typically have a bi-lobed nucleus. Because the granules can be so prominent, the lobation of the nucleus can sometimes be difficult to see
eosinophil
Basophils are by far the rarest of the granulocytes, and are believed to be absent from cats, rats, and mice. In fact, in all species the basophil the rarest of all of the formed elements. Once seen, they’re hard to mistake for any other cell type: in smears they have a deep purple, wine colored look to them, and the granules appear to be on the “outside” of the cell. They aren’t, of course, like any granules they’re intracellular. But the large granules in this rather small cell protrude considerably and stretch the plasma membrane. It sometimes looks as if the basophil had been coated with something and “rolled” in granules. The density of the staining is usually such as to obscure the nucleus, but when it’s visible it usually is S-shaped.
basophil

The lymphocyte is typically the most numerous and most important of the agranulocytes. Lymphocytes come in several sizes, those in the blood being characterized as “small” (5 to 10 microns) or “medium” types (10 to 18 microns). The “large” size is usually found outside the circulation, mostly in lymphatic organs. Lymphocytes can be identified in smears by their very high ratio of nucleus to cytoplasm. The nucleus is very densely stained, and usually round (although it may have a very slight indentation). The cytoplasm is a thin band to one side of the nucleus, and is stained a dusky blue color.
Erythrocyte Morphology
Normal Biconcave disc, dependent on species Most mature mammalian RBCs contain no nucleus
Poikilocytosis
variation in shape
Spherocytes
appear smaller and more dense due to spherical shape – may indicate immune-mediated anemia

Acanthocytes
red cells with several unevenly distributed surface projections, often with knobby ends – may be noted in spleen/liver disorders

Schistocytes
irregular RBC fragments resulting from trauma in circulation
Echinocytes or Crenation
several blunt or pointed evenly spaced surface projections. Usually an artifact of smear technique or age of blood.

Rouleaux
stacking of RBCs; may be associated with immune-mediated disease
lymphocyte

Monocytes are the second type of agranulocyte, and the largest of the circulating formed elements. A healthy monocyte will run anywhere from 16 to 25 microns in diameter, much larger than any other formed element. The nucleus varies in form, and may be kidney shaped, bean shaped, or (classically) horseshoe shaped, with a deep indentation.
The nuclear material of monocytes doesn’t stain as deeply as that of lymphocytes, and chromatin strands can be made out (at least one author has described it—in a remarkably colorful phrase—as a “spaghetti and meatball” nuclear pattern). The ratio of nuclear material to cytoplasm is also less than in the lymphocyte. The cytoplasm of the monocyte will stain a blue-gray color and is said to have a “ground glass” appearance due to the presence of fine granules in it.
Monocytes aren’t common in circulating blood, representing perhaps 5% to 8% of all leukocytes, but you do run across one now and then. When you do spot one, it’s pretty obvious what it is, based on the size alone. In addition, the greater amount of cytoplasm and the deeply indented nucleus (depending on the geometry of the section this may or may not be visible) are confirmation. In the image shown here, the monocyte is by far the largest cell in the field. The indentation of the nucleus isn’t pronounced, thanks to the orientation of the cell with respect to the plane of section, but the very significant amount of cytoplasm visible is: no lymphocyte would have as much. the slate-blue color of the cytoplasm is another clue. This cell is easily three times the size of the erythrocytes that are located near it. This cell was spotted on a slide of the liver, in one of the blood sinusoids; a good place to go hunting for circulating leukocytes.
Be aware that there’s a bit of a size overlap between large lymphocytes and small monocytes. Distinguishing which is which can take some practice and a sharp eye for details like nuclear configuration and colors. The best rule to use is that if you aren’t sure it’s a monocyte….it probably isn’t.
monocyte
The blood of non-mammals is somewhat different: the most conspicuous difference is that all non-mammals have nucleated erythrocytes. The presence of nuclei in mammalian erythrocytes is a sign of pathology, but in non-mammals it’s normal. In this case, the Greek root kytos (for “cell”) has real meaning, because in all non-mammals, the erythrocyte of the circulation is a true cell, complete with nucleus. As in mammals, its function is to carry oxygen to the tissues.
You’ll most commonly encounter non-mammalian blood in the form of avian blood. Avian erythrocytes (and non-mammalian ones in general) are oval in shape, and have a distinct centrally located nucleus. Although size varies somewhat with sex and breed, avian erythrocytes are typically about 6.0-8.0 µ wide and 9.0-12 µ long. The nucleus is strongly basophilic and the cytoplasm eosinophilic. Frequently you will be able to make out a clear area around the nucleus; this is an enlarged perinuclear space. The space is real—it’s present in all nucleated cells—but its enlargement to the point where it can be seen in a light microscope is probably a preparation artifact.
The thrombocyte, also seen in this field from slide 642, is the non-mammalian equivalent of the platelet, and it has the same function of on-the-spot repair of breaks in the vascular system. In some clinical contexts the word “thrombocyte” is used interchangeably with “platelet” in mammals, which strictly speaking isn’t correct usage. In birds, however, it is: the thromobocyte is a true cell, complete with nucleus and other organelles.
Thrombocytes are smaller than erythrocyte and in smears have a faintly bluish tinge to their cytoplasm. One immediately recognizable feature in good preparations is a small eosinophilic vacuole located at one end of the nucleus. It appears as an orange dot in most preparations. This perinuclear “dot” is part of the Golgi appar
blood cell lineage

monocyte species differences
Monocytes are extremely variable in appearance but there are no consistent species differences. Each of the four monocytes shown here as examples are from different species lymphs but all could be found in blood of any individual animal of any species. For example, the canine monocyte shown here would feel equally at home in a smear of horse blood and the cat monocyte could have been in dog blood.
Some monocytes resemble band or segmented neutrophils, as illustrated by the canine moncyte, while others, like this equine monocyte, may be mistaken for lymphocytes. In general, monocytes are recognized as cells that have abundant light to deep blue cytoplasm and nuclei that are not round. Chromatin is reticular or only slightly condensed. Most are larger than neighboring neutrophils and lymphocytes. Small pink granules are visible in some monocytes and many monocytes have several small discrete vacuoles. Nuclear shape amongst monocytes ranges from ameboid to bean-shaped to band-like to almost segmented. The texture of cytoplasm in a monocyte is slightly grainy or coarse compared to lymphocyte cytoplasm, which is very smooth and glassy.

neutrophil species differences
The neutrophil, or the heterophil in birds, reptiles and some mammals, is the predominant granulocyte. In many species it is the predominant leukocyte in health. In health, usually only mature neutrophils are released from marrow to circulate in blood. Since mature neutrophils in prototypical human blood have nuclei that are segmented into lobes of condensed chromatin connected by filaments, mature neutrophils are called segmented neutrophils or segs. The mature neutrophils of many animal species do not have a distinct lobe and filament arrangement (they do have constricted nuclei or irregular/knobbly nuclear outlines), nevertheless, they also are called segmented neutrophils. Neutrophils are part of the innate immune system and are the first line of (and are essential for) defense against bacterial pathogens. Neutrophils have a short half-life - they only persist for 10-15 hours once they have been released into peripheral blood.
Normal mature neutrophils of several species are shown at the right. Canine neutrophils have white cytoplasm that contains small pink specific or secondary granules. Feline neutrophils have cytoplasm that is white and lacks visible granules. Equine neutrophils have white or slightly pink cytoplasm with no visible granules. The nuclei of equine neutrophils typically are long, thin and “knobby” with clumps of condensed chromatin projecting from the sides. Ruminant neutrophils have white cytoplasm with small pink granules; these impart an overall pink tint compared to the other species.
Rabbits, birds, amphibians and reptiles have heterophils. In contrast to the inconspicuous granules of neutrophils, granules in heterophils are large and stained deep orange to red. A typical avian heterophil is shown in the page, “Blood Cells by Species”.